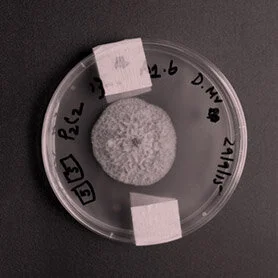
ENDOPHYTE CLUB

11.03.16 - 05.06.16
FIELD TEST
Make hay while the sun shines, or when the sensors say? Will plant and agrifood research innovate to meet global consumption, or will farms change into factories, food forests or even theme parks?

Curators
Lynn Scarff - Ex-Director Of Science Gallery Dublin
Centre for Genomic Gastronomy - Artist Led Think Tank
Advisors
Charles Spillane -
Andrew Douglas - Advisor And Creator Of Urban Farm
Jane Stout - Field test advisor and Professor in Natural Sciences, TCD
Mukund Thattai - Faculty member at The National Centre For Biological Sciences, Bangalore
Nicola Twilley - Author of The Blog Edible Geography And Newyorker.Com writer
Highlights
Exhibits
In a world first, Mark Post of Maastricht University revealed a ‘Cultured Beef’ burger at a press-release event in London in August of 2013…
Each cow in a herd is fitted with a Silent Herdsman smart collar, which monitors its health round-the-clock and transmits the data wirelessly to a computer, mobile or tablet.
Moocall is a calving sensor worn on a cow’s tail that measures over six hundred data points every second to determine the onset of calving.
Coffee is one of the largest globally traded commodities, yet only 1% of the plant biomass ends up in the cup after the final brewing process.
Tinder for Bees is an interactive project that allows visitors to participate in the protection of honey bees.
The Dublin Honey Project is working with native Irish Black Bees to produce honey from each of the Dublin postcodes.
Stir Fly is a contestable domestic appliance that could be used in the kitchen of every home: a prototype of a domestic bioreactor designed to culture and farm in vitro insect meat.
For 10,000 years creative individuals and groups have bred plants, selecting for desired traits and passing this information on through saved seeds.
Second Livestock, a virtual reality world for battery-farmed chickens, is a speculative project drawing parallels between how we treat animals and how we treat ourselves.
From flies to lobsters, small insects and animals have long been ideal models for roboticists and computer scientists.
The Open Agriculture Initiative (OpenAG) at Massachusetts Institute of Technology (MIT) is on a mission to create more farmers for the future of food production…
In Europe and the United States, roughly fifteen percent of the harvest is lost to pests…
The Personal Food Computer is a controlled-environment agriculture technology platform that uses robotic systems to control and monitor climate, energy, and plant growth inside a specialised growing chamber.
In sealed rooms, as sterile as computer-processor factories, chicks hatch while being closely monitored….
The Playing with Pigs project began investigating the complex relationship we have with domesticated pigs by designing a game….
GrassOmeter believes data is the new soil; that soon it will be as important to the farm of tomorrow as the tractor is today.
LOCI Food Lab is a travelling food cart for prototyping, serving, and debating a range of bioregional food futures at different sites around the world…
Searching for a complex object in a world filled with complex objects is difficult for any animal, including insects…
Farmstand Forecast presents emerging trends and fringe products, exemplifying changes that are underway in farming, food processing, and product development.It is laid out in the following sections…
Farm Hack is a worldwide community of farmers that build and modify their own tools through the long-standing farm traditions of tinkering…
A ‘microbiome’ is all of the microorganisms in a particular environment, including the human body or a part of the body….
Foraging is the practice of gathering fruits and vegetables from places other than farms or orchards…
Ash Dieback, a chronic fungal disease first found in Ireland in 2012, poses a fatal threat to ash trees…
Aquaponics refers to any process in which fish and plants are farmed together in one integrated, symbiotic system…
Millions of the world’s smallholder women farmers have limited access to farm energy, mechanisation and the most basic of agricultural and agri-processing tools…